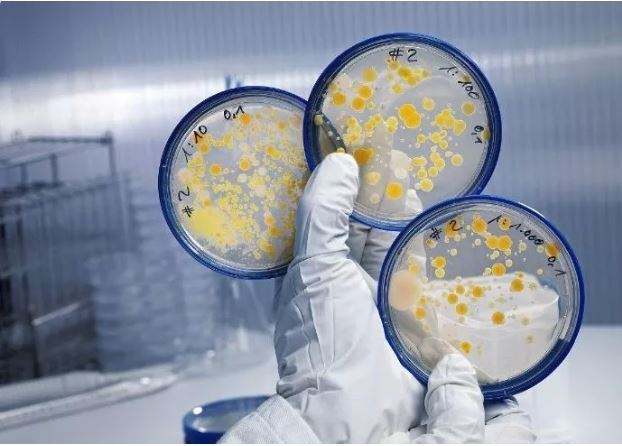
src=http___pica.zhimg.com_v2-a7985a6e5927fe6e558042244558e55d_1440w.jpg_source=172ae18b&refer=http___pica.zhimg.jpg

DW-M80自動(dòng)微生物生化鑒定系統(tǒng)儀器通過(guò)生化反應(yīng)原理(包括酶底物反應(yīng)/糖利用反應(yīng)/同化反應(yīng)/氨基酸實(shí)驗(yàn)等)捕獲細(xì)菌生化表型特征,對(duì)微生物進(jìn)行鑒定。系統(tǒng)配套96孔細(xì)菌生化鑒定及藥敏試驗(yàn)試劑板條,每塊板包含鑒定功能區(qū)和藥敏功能區(qū),其中鑒定功能區(qū)通過(guò)24種生化反應(yīng)一次性將細(xì)菌鑒定至種;藥敏功能區(qū)每次試驗(yàn)可提供20種以上、3個(gè)稀釋度的抗生素藥敏試驗(yàn)結(jié)果,并可實(shí)時(shí)出具鑒定報(bào)告(可報(bào)告MIC)。
【產(chǎn)品特點(diǎn)】
1、數(shù)據(jù)庫(kù)龐大:菌種表型信息庫(kù)2000種以上,可鑒定550種以上微生物,并支持自建庫(kù)。

2、基因數(shù)據(jù)庫(kù):系統(tǒng)可選配在線版全基因組測(cè)序鑒定軟件Microbe Tracker,對(duì)少見(jiàn)菌及疑難菌的單分離菌株基因組序列進(jìn)行系統(tǒng)分析和鑒定報(bào)告。


3、結(jié)果可靠:細(xì)菌生化鑒定一致性95%以上,藥敏試驗(yàn)結(jié)果符合率95%以上。
4、人機(jī)友好:中文頁(yè)面,操作簡(jiǎn)單,4步即可完成鑒定。

5、種類(lèi)豐富:常規(guī)鑒定試劑板和特殊鑒定板種類(lèi)齊全,滿足更多微生物鑒定需求。

6、可定制板條:可針對(duì)特殊需求,專(zhuān)門(mén)定制藥敏試劑板。
【產(chǎn)品應(yīng)用學(xué)科方向】
(1)食品科學(xué)
功能食品與腸道菌群、動(dòng)物源食品微生物質(zhì)量控制、農(nóng)產(chǎn)品檢測(cè)、食源性致病菌風(fēng)險(xiǎn)監(jiān)測(cè)、微生物污染溯源、食品質(zhì)量與安全研究、食品藥品微生物檢驗(yàn)等。

(2)動(dòng)物健康
動(dòng)物源細(xì)菌耐藥性分析、飼料添加劑功能微生物分離及篩選、飼料功能微生物代謝產(chǎn)物分析、動(dòng)物檢疫及畜產(chǎn)品衛(wèi)生檢驗(yàn)、水產(chǎn)品質(zhì)量安全監(jiān)測(cè)、致病菌風(fēng)險(xiǎn)監(jiān)測(cè)、布魯氏菌風(fēng)險(xiǎn)監(jiān)測(cè)和衛(wèi)生檢驗(yàn)等。

(3)公共衛(wèi)生和醫(yī)學(xué)檢驗(yàn)
傳染病相關(guān)病原體鑒定溯源、食源性疾病相關(guān)病原體鑒定溯源、食品安全相關(guān)病原體鑒定溯源、口腔微生態(tài)研究、飲用水水質(zhì)監(jiān)測(cè)、公共場(chǎng)所環(huán)境污染物溯源與控制、微生物耐藥性分析等。

(4)微生物學(xué)與生物技術(shù)
微生物污染鑒定技術(shù)、微生物群落結(jié)構(gòu)分析、微生物種間相互作用機(jī)制研究、生產(chǎn)環(huán)境污染溯源等。